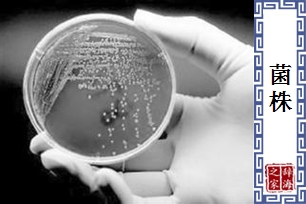
菌株

【菌株】的意思和解释
【菌株】是什么意思(来源:辞书)
- 为微生物分类学上的一个单位,在分类学上微生物可依据界(kingdom)、门(phylum)、纲(class)、目(order)、科(family)、属(genus)、种(species)来分类。其中是将一群分离出来的菌株,彼此间有相似性而与其他菌有明显的不同且能彼此杂交产生具有生育能力的后代者归于同一种。而种以下又以亚种(subspecies)细分其型态的差异,亚种以下再依来源的不同细分为不同的菌株(strain),因此,菌株为一个或一群具有已知型态生物(例如细菌或真菌)的共同特性或某一特别属种之共同特性的细胞。[P. Singleton and D. Sainsburg, Dictionary of Microbiology, 1978]
【菌株】 图片鉴赏
相关词语
查字典的部份资料来自网络或由网友提供,不保留版权,如有侵权,请与我们联系以从站上删除! 免责声明:本站非营利性站点,以方便网友为主,仅供学习。
Tip:SCCG
